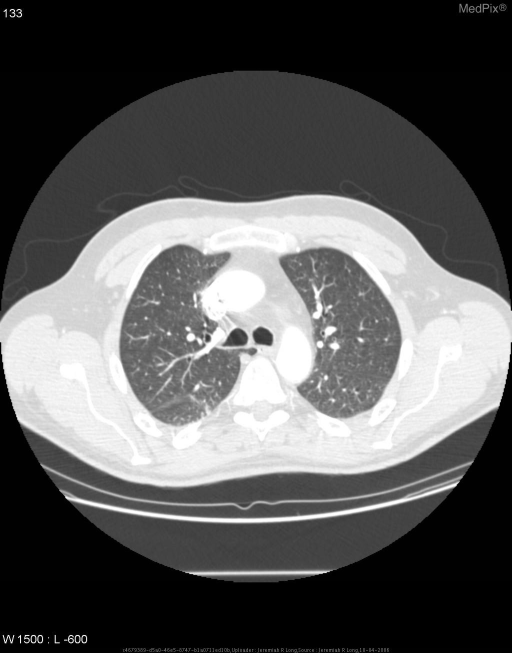

Azygous lobe of lung full details for md exams 15marks
Reading File
Finding Sources
Finding Sources
Finding Sources
Finding Sources
Searching Images
azygous lobe lung chest X-ray CT anatomy
Loading Image
Searching Images
azygous lobe chest X-ray curvilinear line right apex fissure
Loading Image
Loading Image
Here is a comprehensive, exam-oriented write-up on the Azygous Lobe of the Lung — structured for a 15-mark MD answer.
Azygous Lobe of the Lung
Definition
The azygous lobe (also spelled azygos lobe) is a congenital anatomical variant of the right lung in which a small accessory lobe is demarcated in the superomedial portion of the right upper lobe by an anomalous pleural fold — the azygous fissure — created by the displaced azygous vein.
It is not a true lobe in the embryological sense; it has no separate bronchus, artery, or vein. It is simply a portion of the right upper lobe partitioned off by a mesoazygous (pleural fold containing the azygous vein).
Incidence
- Occurs in approximately 0.4–1% of the population (some studies cite up to 1.2%)
- Seen equally in males and females
- Almost exclusively a right-sided anomaly (the azygous vein normally lies on the right)
- Left-sided equivalents (involving the hemiazygous vein) are exceedingly rare
Embryology — Development of the Azygous Lobe
This is the most important aspect for examinations.
Normal Development
During fetal development, the azygous vein (a cardinal vein derivative) normally migrates medially and superiorly, passing over the apex of the right lung to reach its final position in the right tracheobronchial angle, where it arches over the right main bronchus to drain into the superior vena cava (the azygous arch).
Anomalous Development (Azygous Lobe)
If the azygous vein fails to migrate over the lung apex and instead becomes trapped within the developing lung mesenchyme, it drags along its mesentery (the mesoazygous), which consists of four layers of pleura:
- 2 layers of parietal pleura (outer)
- 2 layers of visceral pleura (inner)
This four-layered pleural fold — the azygous fissure — invaginates the right upper lobe from above downward, creating a small medial segment: the azygous lobe.
Key Embryological Fact
The azygous fissure is composed of 4 layers of pleura (2 visceral + 2 parietal) — this is the single most frequently examined fact about this structure.
Anatomy
| Feature | Detail |
|---|---|
| Location | Superomedial aspect of right upper lobe |
| Demarcating structure | Azygous fissure (4-layered pleural fold) |
| Vascular contents of fissure | Azygous vein (displaced superiorly/laterally) |
| Bronchial supply | No separate bronchus — supplied by branches of right upper lobe bronchus |
| Arterial supply | From right upper lobe pulmonary artery branches |
| Venous drainage | Into right upper lobe pulmonary veins |
| Lymphatics | Drain to right paratracheal nodes |
| Size | Variable; typically small (1–3 cm across) |
The lobe lies in the right paratracheal space, medial to the rest of the right upper lobe and lateral to the trachea.
Radiological Appearances
On Chest X-Ray (PA View)
The azygous lobe produces a classic, recognizable pattern:
- A curvilinear line — a fine, comma-shaped or inverted "J"-shaped opaque line in the right upper zone, running from the lateral chest wall medially toward the mediastinum. This is the azygous fissure.
- A teardrop-shaped opacity at the lower end of this line — the azygous vein itself, sitting in a more superior and lateral position than normal.
- A small medially-positioned lung segment (the lobe itself) is visible between the fissure line and the trachea.
Classic description: "A fine curvilinear line ending in a teardrop shadow at the right apex"
On CT Chest
CT is diagnostic and shows:
- The azygous fissure as a distinct 4-layered pleural line in the right lung apex
- The azygous vein at the inferior end of the fissure in a higher position than its normal tracheobronchial groove location
- Normal lung parenchyma within the lobe (no consolidation, no mass)
- CT confirms the benign nature and differentiates it from pathology
CT images below (MedPix) — axial sections showing azygous fissure and ectopic azygous vein:
Axial CT chest (lung window): The curvilinear azygous fissure is seen in the right lung apex, with the teardrop azygous vein at its inferior margin — classic azygous lobe anatomy.
Differential Diagnosis of the Azygous Fissure on CXR
The azygous fissure line must be differentiated from:
| Condition | Distinguishing Feature |
|---|---|
| Pneumothorax | Pleural line parallels chest wall; absence of lung markings laterally |
| Apical pleural thickening/cap | Irregular, ill-defined opacity; no teardrop vein |
| Pulmonary apical scar | Linear opacity; no mobile teardrop shadow |
| Right upper lobe atelectasis | Volume loss; displacement of fissure; hilar elevation |
| Mediastinal mass | Broad, non-linear opacity; compresses structures |
| Pancoast (superior sulcus) tumour | Apical mass with rib erosion, Horner's syndrome |
The teardrop azygous vein at the end of the fissure is pathognomonic — it is not seen in any of the above conditions.
Clinical Significance
Benign Condition
- The azygous lobe is a normal variant with no functional impairment
- Lung parenchyma within it is entirely normal
- No symptoms, no physiological consequences
Important Clinical Points
-
Diagnostic pitfall on CXR — The fissure can be mistaken for a pneumothorax line (especially in ICU chest X-rays), leading to unnecessary chest drain insertion. This is the most important clinical danger.
-
Surgical relevance — During right upper lobectomy or pneumonectomy, the surgeon must recognize and ligate the displaced azygous vein to avoid inadvertent injury and hemorrhage.
-
Central venous catheter placement — A catheter tip can occasionally lodge in the azygous arch; this is more likely to occur with a displaced, superiorly-positioned azygous vein.
-
Bronchoscopic relevance — Since the azygous lobe has no independent bronchus, it cannot be identified bronchoscopically; this helps confirm it is not a true lobe.
-
CT-guided procedures — Awareness prevents erroneous biopsies or needle placements targeting the "lobe" as a mass.
-
Associated anomalies — Rare reports of association with azygous continuation of inferior vena cava (interrupted IVC with azygous continuation), particularly seen in polysplenia syndrome.
Summary Table for Exam Revision
| Parameter | Details |
|---|---|
| Definition | Congenital variant; accessory lung segment in right upper lobe |
| Incidence | ~0.4–1% |
| Side | Right (exclusively, almost always) |
| Embryological cause | Failure of azygous vein to migrate over lung apex |
| Fissure composition | 4 pleural layers (2 visceral + 2 parietal) |
| Separate bronchus? | No |
| Separate artery/vein? | No |
| CXR appearance | Curvilinear line + teardrop opacity at right apex |
| CT appearance | Pleural fold + ectopic azygous vein at higher level |
| Clinical significance | Usually asymptomatic; important diagnostic pitfall |
| Most dangerous misdiagnosis | Confused with pneumothorax → unnecessary chest drain |
| Surgical importance | Ligation of ectopic azygous vein in right thoracic surgery |
Mnemonics
"4-LAYER FISSURE" — 2 Visceral + 2 Parietal pleura = 4 layers total (unique to azygous fissure; major fissures and minor fissures are 2-layered)
"AZYGOUS LOBE = AZTD":
- Anomaly of development
- Zero functional significance
- Teardrop shadow on X-ray
- Don't confuse with pneumothorax
Points Worth 15 Marks — Examiner's Checklist
A full 15-mark answer must cover:
- Definition + classification as a variant, not a true lobe (1 mark)
- Incidence and laterality (1 mark)
- Embryological explanation with normal vs. anomalous vein migration (3 marks)
- Anatomy: pleural layers, no separate bronchus/vessels, location (2 marks)
- CXR appearance with description of curvilinear line + teardrop (2 marks)
- CT appearance (1 mark)
- Differential diagnosis of fissure line (2 marks)
- Clinical significance: surgical, diagnostic pitfalls, catheter, bronchoscopy (2 marks)
- Summary / conclusion (1 mark)
This is a shared conversation. Sign in to Orris to start your own chat.